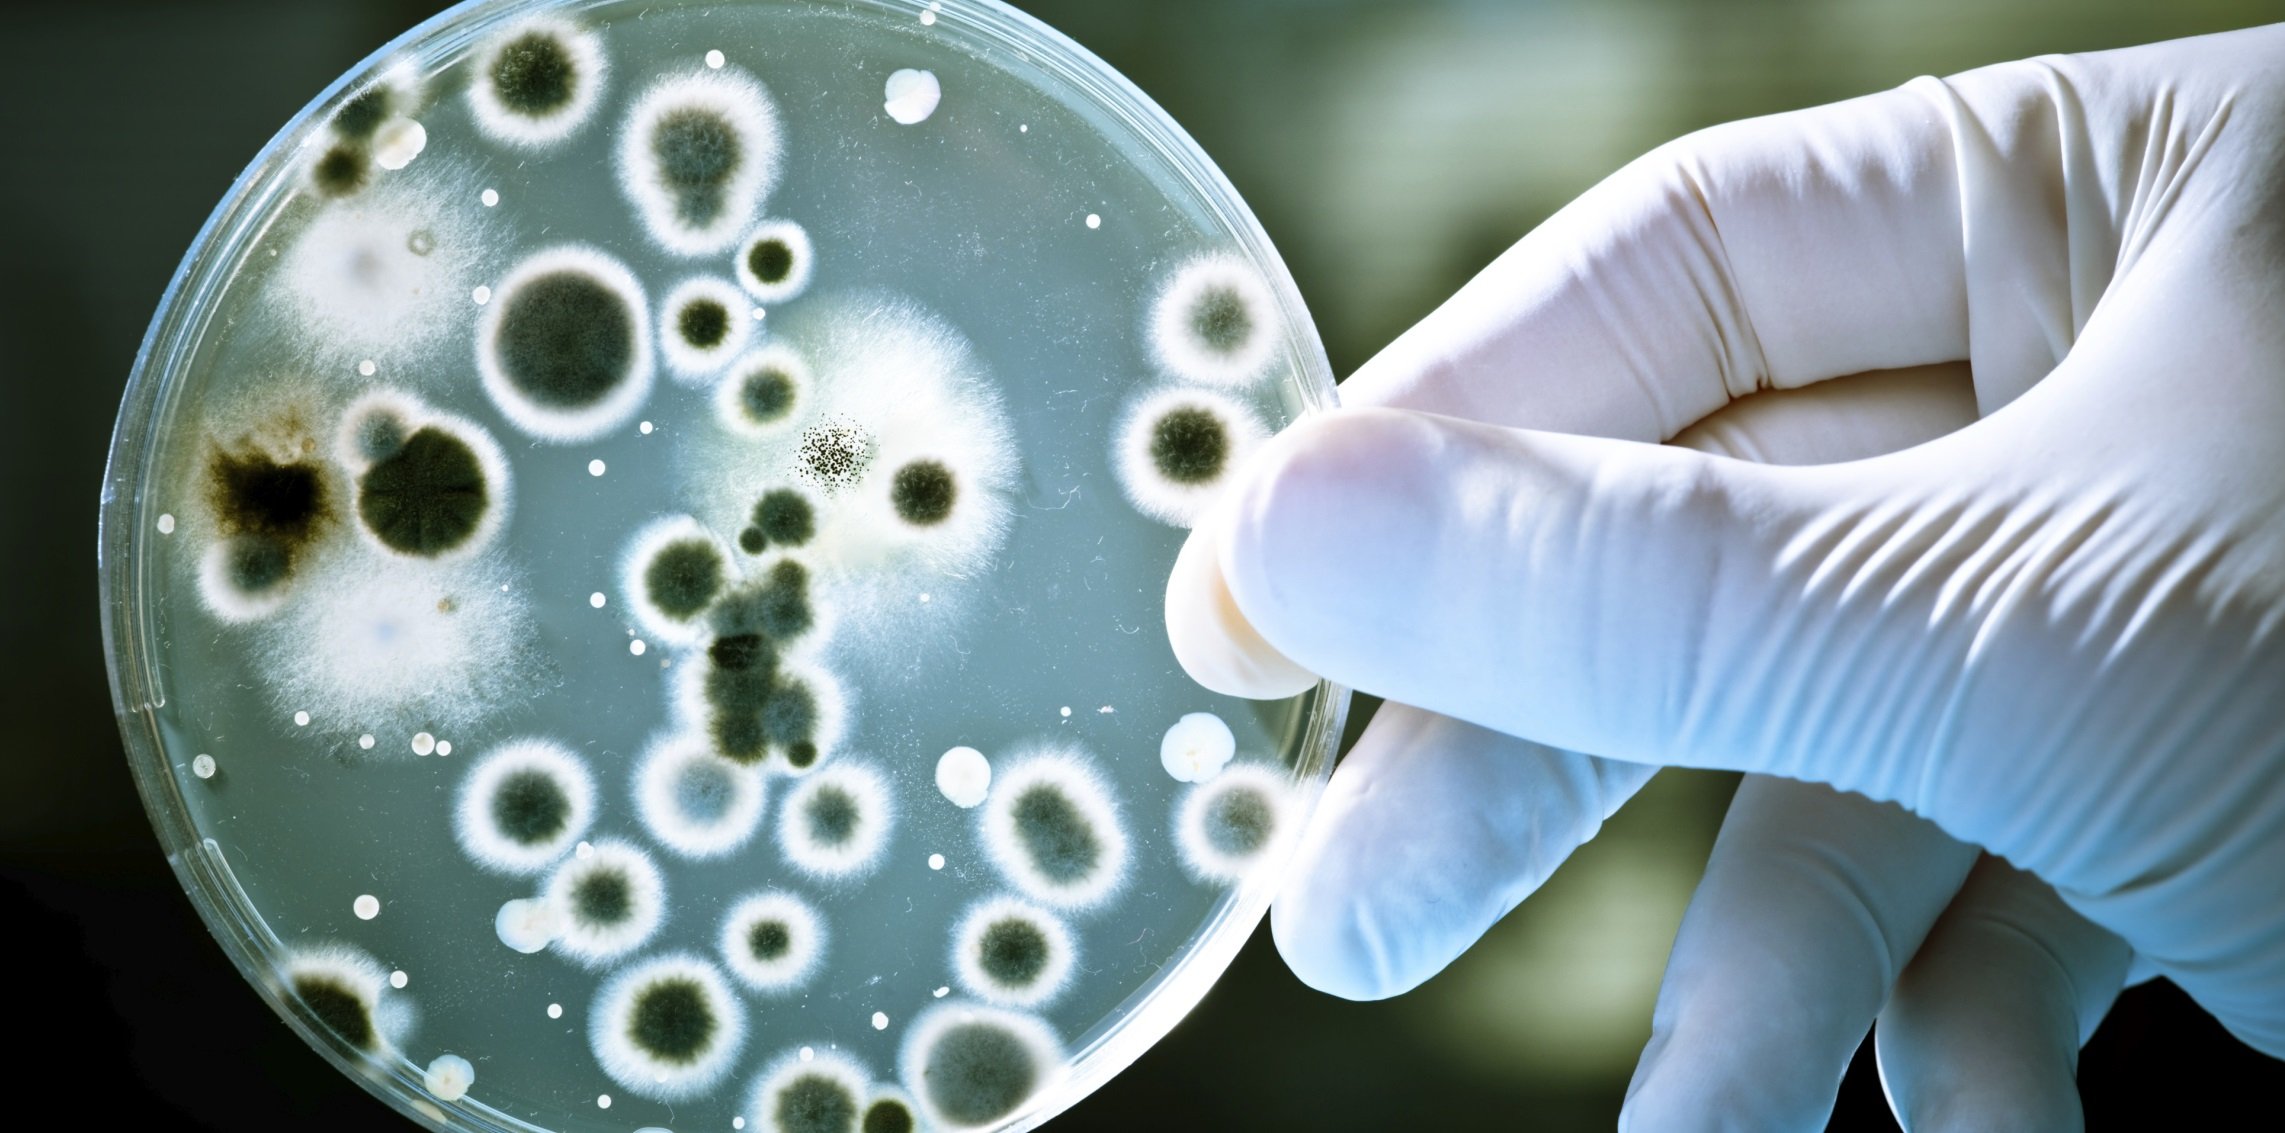

Pishtaz Razak Food industry
Malard Packaging Company (Razak) was founded in Tehran under the name of Lui Monde in September 03, 1980 with an aim to produce authorized food products for exp ...
Website : -
Rezvan Chocolate
Rezvan Chocolate Company, with the aim of providing the best service to esteemed Iranian customers and consumers, has produced more than 40 different types of p ...
Website : -
Shirin Asal
Shirin Asal, over its fast historical development from a small factory to the country s leading confectionery group, has demonstrated an enviable capability to ...
Website : -
Bijan Food Industries
oday, this famous unit has good situation in National Food Industires and has many activities as an industrial group with three subsidiaries in independent fiel ...
Website : http://bijanfood.com
Bake Sanat
Beyk Sanat Company (Private Joint Stock) was established in 1994 with the aim of equipping bulk bread units, confectionery and chocolates to modern machines and ...
Website : -
Fafa food industry group
The Fafa Food Industries Group (Private Joint Stock Company) was founded in 1365 in Neishabur, with emphasis on producing healthy and quality products in the pr ...
Website : -
Kala Koudak Tous
History of Baby Land is the most reputable children's brand in Iran, which strives to improve the way of keeping and caring for children with the latest technol ...
Website : -
Glan
Glan Co. is one of the leading cosmetic companies in Iran that produces cosmetics, detergents, and detergents, as well as related materials. The company's produ ...
Website : -
Paxan
Paxan Corporation is an industrial hygiene and detergents manufacturer in Iran which by utilizing the latest technology and using the professionals, achieved th ...
Website : -
pars Hayat
Established a factory on a land area of 240,000 square meters in Abhar city, Zanjan province. Currently, Pars Hayat Company has started its presence in the Ir ...
Website : -
Khazar Khousheh
Khazar Khoshe Food and Packaging Industries (formerly Quds), with the efforts and cooperation of experts specializing in the green area of Mazandaran, was put i ...
Website : -
malard mushrooms
Melard Agriculture and Technology Co. is one of the most advanced and equipped centers for producing fresh mushrooms and canned mushrooms in Iran, which holds m ...
Website : -
Shokufa Behdasht Arian
Negin Behdasht Aryan Co. was established in 2002 aiming at producing hygienic products to compete with leading domestic and international brands and protect the ...
Website : -
Sehat Industrial
Sehat Industrial and Trading Company was established in 1956 in Tehran. According to the certificate of Iran's Food, Pharmaceutical and Sehat Industries Office, ...
Website : -
Razi Industrial Group
Razi Industrial Group was founded in 1979 and this idea was first formed with the formation of Razi Chemical Company to produce various types of industrial and ...
Website : -
Torsh Afrooz Pak
Torsh Afrooz Pak Co. is developing its products under the brand name "Forest" under the supervision of experienced experts in the food industry and experts of t ...
Website : -
Zarrin Jam Marina
Zarrin Jam Marina Company was established in 2008 with more than one hundred thousand square meter factory area, located in Kaveh Industrial City. Productions w ...
Website : -
Morshed Gohari machine manufacturing
New rotary mini oven machines-floor baking oven-spiral paste machine- dough roller ...
Website : -
Nouboogh Tejarat Iranian
Nouboogh Tejarat Iranian Trading Company officially started its activity as the largest supplier of commercial orders, both domestic and export, since 1402.
...
Website : https://www.akpsho.com/shopview/23388
unilever Iran
With the establishment of the company and the start of its activities more than 100 years ago, we are one of the largest companies producing consumer goods. Our ...
Website : https://www.akpsho.com/shopview/23478
Henkel
...
Website : https://www.akpsho.com/shopview/10807
Behravesh Sarie
BEHRAVESH SARIE company was founded in 1980. This company with an excellent track compromised on the quality and the services provided to the customer. This com ...
Website : http://www.behraveshsarie.com/
Firooz Health Department
Firuz Health Group was established in 1979 with the participation of Johnson & Johnson Company. The United States was the first child healthcare manufacturer in ...
Website : http://www.firooz.com
Eje Fam
This production unit is the first manufacturer of clear baby glycerin soaps in Iran. At present, it produces 12 types of clear soaps with Aegean brand with diff ...
Website : http://www.ejefam.ir/
Honar Aseman Zamin
In the name of the great designer and creator of the universe, he is the creator of everything and he himself is the guardian of everything, verse 62 of Surah Z ...
Website : https://letkashop.com/
paktez
The soap factory of Youssefi has started the production of bath soap called Azarbyjan in 1908 in Tabriz. In 1913 by purchasing a few semi-automatic equipments f ...
Website : http://paktez.com/